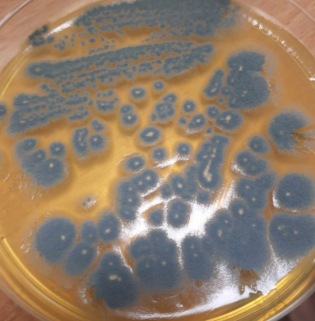
term image

Grzyby - preparaty i info
1/46
There's no tags or description
Looks like no tags are added yet.
Name | Mastery | Learn | Test | Matching | Spaced |
|---|
No study sessions yet.
47 Terms

Lycogala epidendrum ;
Gr.: MYXOMYCOTA
Kl.: Myxomycetes


Diachea leucopodia
Gr.: MYXOMYCOTA
Kl.: Myxomycetes


Hemitrichia serpula
Gr.: MYXOMYCOTA
Kl.: Myxomycetes


Hemitrichia serpula
Gr.: MYXOMYCOTA
Kl.: Myxomycetes


Trichia sp
Gr.: MYXOMYCOTA
Kl.: Myxomycetes


Trichia sp
Gr.: MYXOMYCOTA
Kl.: Myxomycetes


Plasmopara viticola; + powoduje chorobę: mączniak rzekomy winorośli
Gr.: OOMYCOTA


Plasmopara viticola; + powoduje chorobę: mączniak rzekomy winorośli
Gr.: OOMYCOTA


Albugo candida
Gr.: OOMYCOTA


Synchytrium endobioticum
Gr: SYNCHYTRIOMYCOTA
Podgr.: SYNCHYTRIOMYCOTINA


Synchytrium endobioticum
Gr: SYNCHYTRIOMYCOTA
Podgr.: SYNCHYTRIOMYCOTINA


Rhizopus sp
Gr.: MUCOROMYCOTA – grzyby sprzężniowe
Podgr.: MUCOROMYCOTINA


Rhizopus sp
Gr.: MUCOROMYCOTA – grzyby sprzężniowe
Podgr.: MUCOROMYCOTINA


Taphrina deformans
Gr.: ASCOMYCOTA – grzyby workowe
Podgr.: TAPHRINOMYCOTINA


Saccharomyces cerevisiae: saprotrof; pączkujące komórki
Gr.: ASCOMYCOTA – grzyby workowe
Podgr.: SACCHAROMYCOTINA


Penicillium sp.
Gr.: ASCOMYCOTA – grzyby workowe
Podgr.: PEZIZOMYCOTINA

Penicillium sp.
Gr.: ASCOMYCOTA – grzyby workowe
Podgr.: PEZIZOMYCOTINA


Phyllactinia guttata (klejstotecjum)
Gr.: ASCOMYCOTA – grzyby workowe
Podgr.: PEZIZOMYCOTINA


Phyllactinia guttata (klejstotecjum)
Gr.: ASCOMYCOTA – grzyby workowe
Podgr.: PEZIZOMYCOTINA


Rhytisma acerinum
Gr.: ASCOMYCOTA – grzyby workowe
Podgr.: PEZIZOMYCOTINA


Claviceps purpurea
Gr.: ASCOMYCOTA – grzyby workowe
Podgr.: PEZIZOMYCOTINA


Xylaria polymorpha (perytecjum)
Gr.: ASCOMYCOTA – grzyby workowe
Podgr.: PEZIZOMYCOTINA


Xylaria polymorpha (Perytecjum)
Gr.: ASCOMYCOTA – grzyby workowe
Podgr.: PEZIZOMYCOTINA


Peziza sp.
Gr.: ASCOMYCOTA – grzyby workowe
Podgr.: PEZIZOMYCOTINA


Peziza sp. (8 zarodników)
Gr.: ASCOMYCOTA – grzyby workowe
Podgr.: PEZIZOMYCOTINA


Morchella sp.
Gr.: ASCOMYCOTA – grzyby workowe
Podgr.: PEZIZOMYCOTINA


Tuber sp.
Gr.: ASCOMYCOTA – grzyby workowe
Podgr.: PEZIZOMYCOTINA


Agaricus bisporus;
Gr.: BASIDIOMYCOTA
Podgr.: AGARICOMYCOTINA
Kl.: Agaricomycetes
Rz.: Agaricales


Macrolepiota procera;
Gr.: BASIDIOMYCOTA
Podgr.: AGARICOMYCOTINA
Kl.: Agaricomycetes
Rz.: Agaricales


Lycoperdon sp.
Gr.: BASIDIOMYCOTA
Podgr.: AGARICOMYCOTINA
Kl.: Agaricomycetes
Rz.: Agaricales


Geastrum sp.
Gr.: BASIDIOMYCOTA
Podgr.: AGARICOMYCOTINA
Kl.: Agaricomycetes
Rz.: Geastrales


Phallus impudicus
Gr.: BASIDIOMYCOTA
Podgr.: AGARICOMYCOTINA
Kl.: Agaricomycetes
Rz.: Phallales


Hydnum rufescens
Gr.: BASIDIOMYCOTA
Podgr.: AGARICOMYCOTINA
Kl.: Agaricomycetes
Rz.: Cantharellales


Cantharellus cibarius
Gr.: BASIDIOMYCOTA
Podgr.: AGARICOMYCOTINA
Kl.: Agaricomycetes
Rz.: Cantharellales


Fomitopsis pinicola
Gr.: BASIDIOMYCOTA
Podgr.: AGARICOMYCOTINA
Kl.: Agaricomycetes
Rz.: Polyporales


Auricularia auricula-judae
Gr.: BASIDIOMYCOTA
Podgr.: AGARICOMYCOTINA
Kl.: Agaricomycetes


Boletus sp
Gr.: BASIDIOMYCOTA
Podgr.: AGARICOMYCOTINA
Kl.: Agaricomycetes
Rz.: Boletales


Scleroderma citrinum
Gr.: BASIDIOMYCOTA
Podgr.: AGARICOMYCOTINA
Kl.: Agaricomycetes
Rz.: Boletales


Puccinia graminis (ecjum)
Gr.: BASIDIOMYCOTA – grzyby podstawkowe
Podgr.: PUCCINIOMYCOTINA
Kl.: Pucciniomycetes
Rz.: Pucciniales


Puccinia graminis (spermogonia)
Gr.: BASIDIOMYCOTA – grzyby podstawkowe
Podgr.: PUCCINIOMYCOTINA
Kl.: Pucciniomycetes
Rz.: Pucciniales


Puccinia graminis
Gr.: BASIDIOMYCOTA – grzyby podstawkowe
Podgr.: PUCCINIOMYCOTINA
Kl.: Pucciniomycetes
Rz.: Pucciniales

Puccinia graminis (TELIA)
Gr.: BASIDIOMYCOTA – grzyby podstawkowe
Podgr.: PUCCINIOMYCOTINA
Kl.: Pucciniomycetes
Rz.: Pucciniales


Puccinia graminis (TELIA)
Gr.: BASIDIOMYCOTA – grzyby podstawkowe
Podgr.: PUCCINIOMYCOTINA
Kl.: Pucciniomycetes
Rz.: Pucciniales


Phragmidium violaceum
Gr.: BASIDIOMYCOTA – grzyby podstawkowe
Podgr.: PUCCINIOMYCOTINA
Kl.: Pucciniomycetes
Rz.: Pucciniales


Mycosarcoma maydis
Gr.: BASIDIOMYCOTA
Podgr.: USTILAGINOMYCOTINA
Kl.: Ustilaginomycetes
Rz.: Ustilaginales


Tremella sp.
Gr.: BASIDIOMYCOTA
Podgr.: AGARICOMYCOTINA
Kl.: Tremellomyctes
Rz.: Tremellales


Exidia sp
Gr.: BASIDIOMYCOTA
Podgr.: AGARICOMYCOTINA
Kl.: Tremellomyctes
Rz.: Tremellales
